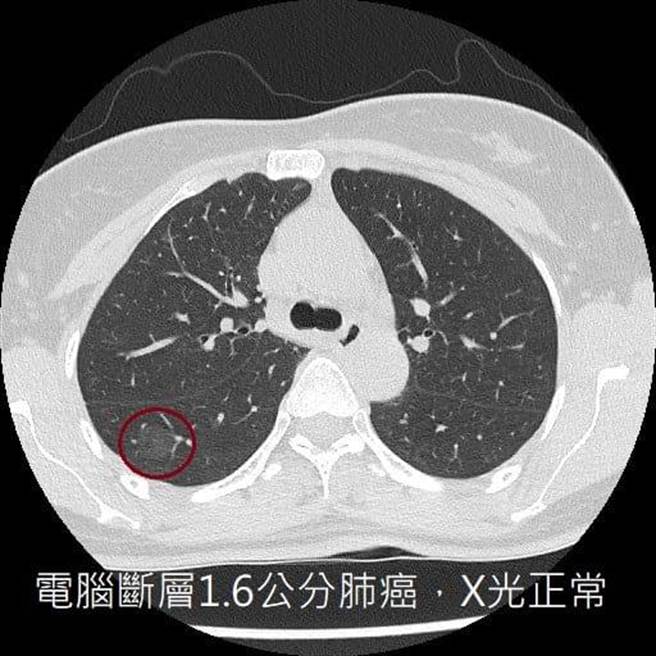
医师分享病患状况，提醒X光正常不等于没有肺癌。（翻摄苏一峰脸书）

别以为不抽菸就不会得肺癌,事实上,近年来已有不少这辈子没抽过菸的人,一检查才发现罹患肺癌。
「千万不要以为X光正常就等于没有肺癌」,医师苏一峰脸书分享,一名中年妇女不抽菸、常煮菜,在无症状的情况下,安排电脑断层,一照竟发现「1.6公分的肺癌」。
苏一峰指出,对于早期肺癌患者来说,胸部X光已不是一个够敏感的检查工具,因为它只能找到大于1、2公分的病灶,且病灶还不能躲在骨头、心臟大血管或横膈等器官的死角位置,被挡住就看不见了。
他呼吁大家,不要以为胸部X光正常等于没有肺癌,除了维持良好生活习惯,一旦身体不适,最好安排更仔细的检查,及早发现、及早治疗。
发表意见
中时新闻网对留言系统使用者发布的文字、图片或檔案保有片面修改或移除的权利。当使用者使用本网站留言服务时,表示已详细阅读并完全了解,且同意配合下述规定:
违反上述规定者,中时新闻网有权删除留言,或者直接封锁帐号!请使用者在发言前,务必先阅读留言板规则,谢谢配合。